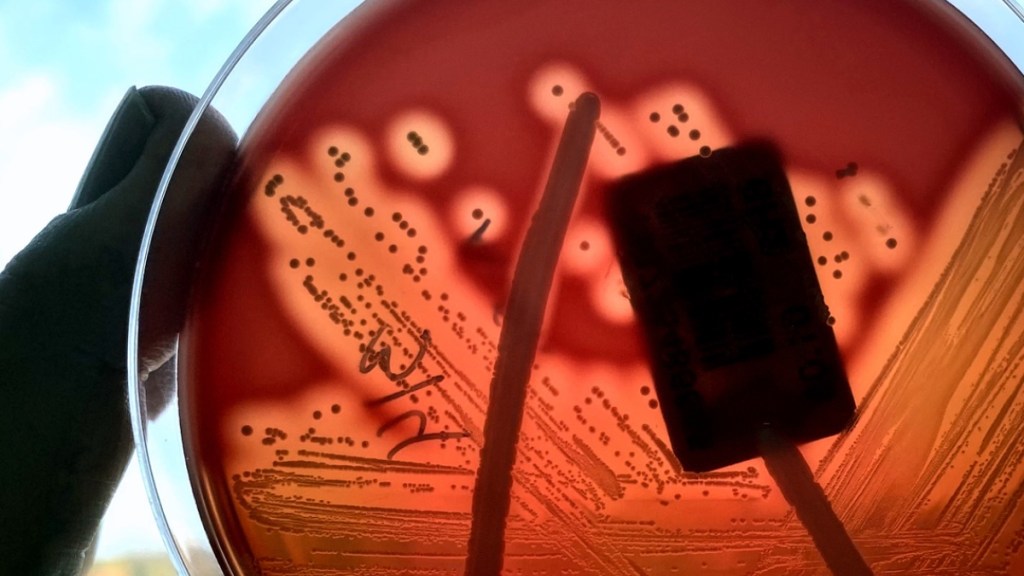
Le taux d'infection au streptocoque A est en hausse au Québec.

Les infections graves à streptocoque A continuent de faire des ravages dans le monde, avec une augmentation des cas de cette maladie potentiellement mortelle. Le Québec n’est pas épargné, avec une hausse de 56 % du nombre de cas de cette infection par rapport à la moyenne d’avant la pandémie de COVID-19.
Entre la fin août 2022 et le 11 février 2023, 327 cas ont été signalés, contre une moyenne de 223 cas pour la même période entre 2015 et 2019, rapportait CBC News. Les enfants et les personnes âgées ont été particulièrement touchés, avec plusieurs décès signalés dans la province.
Le streptocoque A est une bactérie courante, souvent inoffensive, qui peut causer des maladies bénignes comme la pharyngite streptococcique ou la scarlatine. Cependant, lorsque la bactérie pénètre dans le sang ou les tissus profonds, elle peut causer des infections graves et potentiellement mortelles comme la fasciite nécrosante ou le syndrome de choc toxique.
Interrogée par le média anglophone CBC, la spécialiste des maladies infectieuses pédiatriques de l’hôpital Sainte-Justine de Montréal, Dr Fatima Kakkar, a expliqué que l’hôpital est sous pression en raison de la hausse des cas de streptocoque A, en particulier chez les enfants qui ont été épargnés par la maladie ces dernières années et qui présentent une immunité plus faible.
Pénurie d’antibiotiques
Le Québec n’est pas le seul endroit touché par cette hausse. Les chiffres de l’Ontario montrent également une augmentation du nombre de cas cette année, avec plus de 500 cas signalés à la fin du mois de février. La hausse a été observée chez toutes les tranches d’âge, comparativement à la période des cinq dernières années avant la pandémie de COVID-19. Les États-Unis ont également signalé des cas élevés chez les enfants dans certaines régions du pays.
Les symptômes peuvent inclure des lésions cutanées et des lésions des tissus mous, pouvant conduire à des amputations ou même à la mort en l’espace de 12 à 24 heures.
Bien que les infections graves à streptocoque A soient rares, les experts médicaux mettent en garde contre cette maladie potentiellement mortelle. La bactérie se propage facilement par les gouttelettes respiratoires, mais la plupart des gens ne développent qu’une maladie bénigne, voire ne savent même pas qu’ils sont infectés.
Le Canada est également confronté à une pénurie d’amoxicilline liquide, un antibiotique couramment prescrit aux enfants pour traiter les infections à streptocoque A moins graves. Bien que l’amoxicilline ne soit pas utilisée pour traiter les infections à streptocoque A graves, cette pénurie pourrait avoir un impact sur la capacité des pharmaciens à fournir des médicaments à ceux qui en ont besoin.